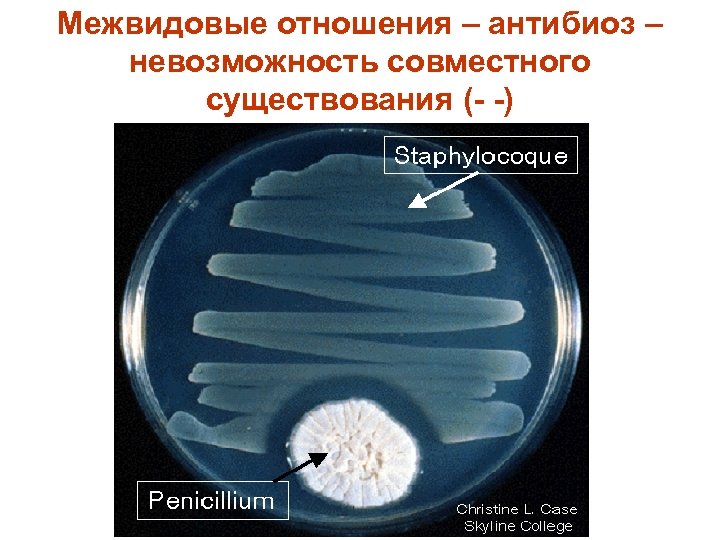
Межвидовые отношения – антибиоз – невозможность совместного существования (- -)

1e243b97640db3d2e55ae92851ad38f2.ppt
- Количество слайдов: 67

Лекция 1

Биогеоценотический уровень организации живого

Паразитология является частью экологии. Экология – наука о взаимоотношении организмов со средой обитания. (от греч. οικος — дом, хозяйство, обиталище и λόγος — учение, наука). Термин впервые предложил в 1866 году немецкий биолог Эрнст Геккель

Эрнст Генрих Геккель нем. Ernst Heinrich Philipp August Haeckel Дата рождения: 16 февраля 1834 Дата смерти: 9 августа 1919 Гражданство: Германия Научная сфера: Естествознание Место работы: Йенский университет Берлинский университет, Вюрцбургский Альма-матер: университет, Венский университет

Экология включает следующие основные разделы: • Аутэкология – экология отдельных организмов; • Популяционная экология; • Синэкология – экология сообществ.

Экология организмов (аутэкология) изучает действие на живые организмы факторов окружающей среды. Экологический фактор - это любой элемент среды, оказывающий прямое или косвенное влияние на живые организмы.

организмов Для каждого фактора существует зона оптимума, а также верхний и нижний предел выносливости.

То же, чуть более образно

Экологические факторы делят на: • абиотические факторы - влияния неживой природы (климатические факторы); • биотические факторы - влияния живой природы; • антропогенные факторы - влияния, вызванные разумной и неразумной деятельностью человека.

Для жизни особи важно сочетание экологических факторов (экологическая ниша) Немецкий химик Либих открыл один из фундаментальных законов экологии — закон ограничивающего фактора (известный как «бочка Либиха» ). Юстус Либих (1803 – 1873)

Закон ограничивающего фактора или закон минимума Либиха — один из фундаментальных законов в экологии, гласящий, что наиболее значим для организма тот фактор, который более всего отклоняется от оптимального его значения. По имени учёного названо образное представление этого закона — так называемая «бочка Либиха» . Суть модели состоит в том, что вода при наполнении бочки начинает переливаться через наименьшую доску в бочке и длина остальных досок уже не имеет значения.

Мы сейчас не будем касаться абиотических и антропогенных факторов. Рассмотрим биотические факторы, то есть влияние одних живых организмов на другие.

Формы биотических связей в природе. Внутривидовые • Конкуренция • Кооперация Межвидовые • Антибиоз • Симбиоз

Груминг – пример внутривидовой кооперации

Внутривидовая кооперация у человека. И. Е. Репин. Хирург Павлов в операционном зале

Внутривидовая конкуренция

Внутривидовая конкуренция у человека
Межвидовые отношения – антибиоз – невозможность совместного существования (- -)

Симбиоз (в широком смысле слова) – совместное существование видов Вред (-), Вид отношений польза (+) + + Протокооперация, симбиоз (в узком смысле слова) = мутуализм + 0 Комменсализм, квартирантство - 0 Аменсализм 0 0 Нейтрализм - - Конкуренция + - Хищничество, паразитизм

Конечно, такое деление достаточно условно, поскольку все отношения посвоему уникальны…

Протокооперация (++) – совместное существование видов, выгодное обоим, но не обязательное для них. http: //www. flickr. com/photos/cindihachey/2769119120/

Мутуализм ++ – актинии и рыбыклоуны (взаимная защита + пищевые отношения)

Мутуализм ++ – простейшие живут в кишечнике термитов, переваривают для них целлюлозу и надёжно защищены

Мутуализм (++) взаимовыгодные отношения, обязательные для партнёров: микориза (гриб и дерево), лишайник (гриб и водоросль)

Комменсализм +0: крупный рогатый скот равнодушно вспугивает насекомых, которых едят птицы Ротовая амёба живёт и питается у нас во рту, не причиняя вреда.

Таракан наш квартирант или всётаки паразит?

Конкуренция -- между двумя видами ящериц привела к разделению их мест обитания

Ещё пример межвидовой конкуренции

Нейтрализм 00 – верблюд и щитень, способный жить в эфемерных водоёмах. Оба обитают в пустыне Гоби, но никак не взаимодействуют

Аменсализм 0 - – большое дерево не даёт возможности расти мелким растениям, но само не испытывает трудностей.

Хищничество +- – однократное использование жертвы

Паразитизм +-: паразит питается за счёт хозяина и причиняет ему вред

Широко ли распространён паразитизм?

Да…

Красным обозначены группы, представленные свободноживущими видами, зелёным – группы, включающие паразитические виды. Обозначены синим и пронумерованы полностью паразитические группы

Число людей, зараженных паразитами 1. Простейшие Parasitic infection амебиаз Population currently infected 1% of world population лямблиоз 200 million малярия 400 - 490 million лейшманиоз 1. 2 million Болезнь Чагаса 24 million Африканская сонная болезнь 100 000 new cases per year

2. Гельминты аскаридоз анкилостомоз трихоцефалез шистосомоз Филяриаз (вухерериоз) цестодозы стронгилоидоз описторхоз фасциолопсиаз парагонимоз 1. 3 billion 900 million 150 million 128 million 65 million 35 million 13. 5 million 10 million

Происхождение паразитизма. • Паразитизм – вторичное явление. Все паразиты произошли от свободноживущих предков. • Существуют различные пути перехода к паразитизму.

1. От хищничества, если жертва становится слишком крупной. Конская пиявка для водных видов, например, головастиков, - хищник, а для крупных млекопитающих временный паразит

2. От комменсализма. • Предки пухоедов (паразитов птиц) питались органическими остатками в гнезде, затем перешли на тело хозяев и у пеликана стали питаться кровью и жить в мешке под клювом.

3. Вследствие случайного заноса в желудочно-кишечный тракт прежде свободно живущих форм. • Личинки желудочного овода

4. От квартирантства • Все трематоды (сосальщики) имеют моллюсков в качестве хозяев. Личинки сосальщиков когда-то обитали в водоёмах, используя в качестве укрытия раковины моллюсков. В дальнейшем такие квартиранты переселились внутрь тела моллюска.

5. От наружного к внутреннему паразитизму • Черви, паразитировавшие на жабрах рыб, перешли в ротовую полость и далее по пищеварительному тракту. Таким путем могли возникнуть классы цестод (ленточных червей). Широкий лентец

6. При поедании старого хозяина (например, рыбы) новым человек плотоядные пресноводная рыба яйцо личинка циклоп У витрины с широким лентецом

7. Путём удлинения сроков питания • Членистоногие, питавшиеся соками растений, переходят к кровососанию. • Так, самка москита пьёт кровь менее 1 минуты, клещи – до 2 недель, вши становятся постоянными паразитами и проводят на хозяине всю жизни.

Черты паразита: • Паразитизм – это видовой признак • Паразит меньше хозяина • Паразит физиологически зависит от хозяина • Репродуктивный потенциал паразита выше, чем у хозяина, и при сильном заражении паразит может убить хозяина.

Адаптации к паразитизму Прогрессивные • Связаны с более сильным развитием органов паразита или приобретением новых органов Регрессивные • Связаны с редукцией или исчезновением органов паразита

Примеры прогрессивных адаптаций • Размеры паразитов обычно увеличиваются по сравнению со свободно живущими предками (что объясняется обилием пищи) • Форма тела – плоская, что обеспечивает лучшее прилегание или удлиненная, как у тех, кто живёт в просвете сосудов

Что появляется: • Органы прикрепления, питания или проникновения в тело хозяина • Прочные кожные покровы, препятствующие перевариванию • Ёмкий пищеварительный канал • Огромная плодовитость и способность к размножению на личиночных стадиях • Сближение с хозяином (цвет, антигенные свойства, синхронизация жизненных ритмов)

Примеры дегенерации (регресса) • Утрата органов, свойственных свободно живущим предкам (глаз, крыльев, даже кишечника) • Упрощение нервной системы • Преобладание анаэробных процессов обмена веществ

Классификации паразитов

1. По систематической принадлежности • Грибы, бактерии и вирусы изучаются микробиологией и относятся к инфекциям. • Простейшие, гельминты (паразитические черви) и членистоногие изучаются в разделе паразитологии и относятся к инвазиям.

2. По локализации у хозяина 1. Наружние (эктопаразиты) 2. Внутренние (эндопаразиты) • Внутриклеточные (простейшие) • Полостные (живут к просвете полых органов и различных полостях) • Тканевые (крове-тканепаразиты) • Вкожные ( в толще кожи, например – чесоточный клещ)

3. По времени контакта с хозяином • Временные (живут свободно, но поблизости от хозяина и приходят попитаться – комары, клопы) • Постоянные (и едят и живут на хозяине) Стационарные – жизнь вне хозяина невозможна (трихинелла) Ларвальные – паразитирует только личинка (оводы) Периодические – часть жизни проходит во внешней среде Имагинальные – паразитируют взрослые (блохи)

4. По степени специфичности • Эвриксенные (могут паразитировать у многих видов) • Стеноксенные (у узкой группы видов) • Моноксенные (паразитируют только у одного вида)

5. По природе паразитизма Истинные Мнимые – например, на фекалии пациента отложили яйца мухи Факультативные – могут Облигатные, т. е. вести свободный образ «обязанные» жизни, но, при случае, быть паразитами не прочь стать Их-то мы и изучаем! паразитом – например, угрица кишечная Ложные (случайные) – огуречный цепень – паразит собак и кошек, может попасть к человеку

6. По особенностям жизненного цикла • Без смены хозяев • Со сменой хозяев

Комар - эвриксенный временный эктопаразит

Примеры случайного (ложного) паразитизма Огуречный цепень – постоянный стационарный стеноксенный паразит плотоядных. Блоха – промежуточный хозяин

Собака – основной хозяин огуречного цепня, промежуточный – блоха. Человек заражается, случайно проглотив блоху.

Взрослые особи токсокары Токсокара – тоже ложный паразит человека, в норме паразитирует у плотоядных. Дети заражаются, играя с котятами и щенками

конец

Effects of the host upon the parasite • Cellular reactions (macrophages that ingest Leishmaniae enlarge) • Tissue reactions (a capsule is formed around Trichinella) • Immune reactions (antibodies are produced)

Adaptations to parasitism • Specialized attachment organs (hooklets and suckers of tapeworms, claws of lice)

Cercaria – trematode’s larva


1e243b97640db3d2e55ae92851ad38f2.ppt